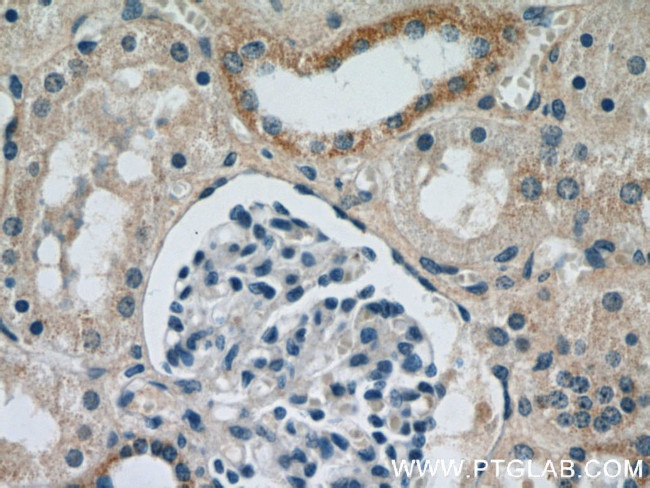
SPPL2A Antibody in Immunohistochemistry (Paraffin) (IHC (P))
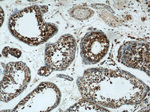
SPPL2A Antibody in Immunohistochemistry (Paraffin) (IHC (P))

Search
Proteintech
SPPL2A Polyclonal Antibody
{{$productOrderCtrl.translations['antibody.pdp.commerceCard.promotion.promotions']}}
{{$productOrderCtrl.translations['antibody.pdp.commerceCard.promotion.viewpromo']}}
{{$productOrderCtrl.translations['antibody.pdp.commerceCard.promotion.promocode']}}: {{promo.promoCode}} {{promo.promoTitle}} {{promo.promoDescription}}. {{$productOrderCtrl.translations['antibody.pdp.commerceCard.promotion.learnmore']}}
产品信息
13255-1-AP
种属反应
宿主/亚型
分类
类型
抗原
偶联物
形式
浓度
规格
纯化类型
保存液
内含物
保存条件
运输条件
产品详细信息
Immunogen sequence: ITKNGESIM VELAAGPFGN NEKLPVVIRV PKLIYFSVMS VCLMPVSILG FGDIIVPGLL IAYCRRFDVQ TGSSYIYYVS STVAYAIGMI LTFVVLVLMK KGQPALLYLV PCTLITASVV AWRRKEMKKF WKGNSYQMMD HLDCATNEEN PVISGEQIVQ Q (361-520 aa encoded by BC025740)
靶标信息
By searching sequence databases for homologs of Dictyostelium discoideum Impas, which shares homology with presenilin, followed by PCR of lymphocyte and hippocampus cDNA libraries, Grigorenko et al. (2002) cloned SPPL2a. This protein, which may act as an intramembrane protease, contains an N-terminal protease-associated (PA) domain, several transmembrane regions, a hydrophilic loop, conservative sequences around the first and second aspartate residues, and an invariant PAL motif near the C terminus.
仅用于科研。不用于诊断过程。未经明确授权不得转售。
篇参考文献 (0)
生物信息学
蛋白别名: IMP-3; IMPAS; intramembrane cleaving protease; Intramembrane protease 3; Presenilin-like protein 2; protein SPPL2a; Signal peptide peptidase-like 2A; SPP-like 2A; SPP-like 2A protein; SPPL2a protein; unnamed protein product
基因别名: 2010106G01Rik; C130089K23Rik; IMD86; IMP3; MNCb-3763; PSEC0147; PSL2; RGD1563001; SPPL2A
UniProt ID: (Human) Q8TCT8, (Mouse) Q9JJF9
Entrez Gene ID: (Human) 84888, (Rat) 311401, (Mouse) 66552